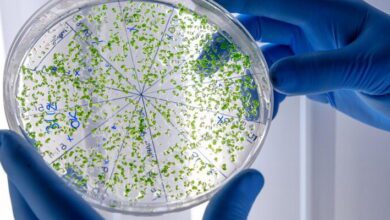
Microbial Ecology MCQs

Gene Expression and Regulation MCQs with Answers

| In cellular biology, the most basic functions that explain how genetic information is managed into protein and other required molecules are gene expression and regulation. Gene expression is defined as the process of using the information found in a gene to synthesize a gene product that is functional, commonly a protein. It usually involves two major processes: transcription, whereby DNA gets converted into messenger RNA (mRNA), and translation, whereby mRNA gets used to construct proteins. Gene regulation is central to functional and plastic cellular properties. It should permit appropriate gene expression at the appropriate times and in appropriate amounts so that the cell can appropriately respond to environmental and developmental cues. Important mechanisms of gene regulation include transcriptional control, primarily through regulatory protein and enhancer action on initiation of transcription, and post-transcriptional control, involving mRNA splicing, stability, and degradation. All of these involve epigenetic modifications, DNA methylation, and modification of the histone associated with the chromatin that change the chromatin structure and access to regulate gene expression without any change in the DNA sequence but with long-term changes in gene expression. Gene expression and regulation are the most important aspects in the development of medical research, especially in the light of targeted therapies, like anticancer therapy and disorders with genetic association. With the manipulation of gene expressions, scientists can reveal the new treatments and much more about intricate biological processes. |
Gene Expression and Regulation Online Quiz
By presenting 3 options to choose from, Gene Expression and Regulation Quiz which cover a wide range of topics and levels of difficulty, making them adaptable to various learning objectives and preferences. You will have to read all the given answers of Gene Expression and Regulation Questions and Answers and click over the correct answer.
- Test Name: Gene Expression and Regulation MCQ Quiz Practice
- Type: Quiz Test
- Total Questions: 40
- Total Marks: 40
- Time: 40 minutes
Note: Answer of the questions will change randomly each time you start the test. Practice each quiz test at least 3 times if you want to secure High Marks. Once you are finished, click the View Results button. If any answer looks wrong to you in Quizzes. simply click on question and comment below that question. so that we can update the answer in the quiz section.
Download Certificate of Quiz Gene Expression and Regulation
On the end of Quiz, you can download the certificate of the quiz if you got more than 70% marks. Add a certificate to your job application or social profile (like LinkedIn) and get more job offers.
If you are interested to enhance your knowledge regarding English, Physics, Chemistry, and Computer please click on the link of each category, you will be redirected to dedicated website for each category.